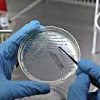

Для уточнения цены и услуги выберите подраздел в начале страницы.
Запись
1100₽
+7(343 ..показать +7(499) 11-68-239+7(343) 311-25-01
МЦ Панацея на Заводской Екатеринбург; ул. Заводская, д. 32, корп. 2 ; м. Площадь 1905 года
Запись
1500₽
+7(343 ..показать +7(499) 11-68-239+7(343) 288-52-00
Клиника Уральская на Уральской Екатеринбург; ул. Уральская, д. 57, корп. 2 ; м. Уральская
Запись
1500₽
+7(343 ..показать +7(499) 11-68-239+7(343) 363-61-64
Центр Эко-Партус на Белинского Екатеринбург; ул. Белинского, д. 61 ; м. Геологическая
Запись
1500₽
+7(343 ..показать +7(499) 11-68-239+7(343) 288-52-00
Клиника Уральская на Чекистов Екатеринбург; ул. Чекистов, д. 16 ; м. Машиностроителей
Запись
1700₽
+7(499 ..показать +7(499) 11-68-239
МЦ Время на Большом Сампсониевском проспекте Санкт-Петербург; Б. Сампсониевский пр-т, д. 60А ; м. Выборгская
Запись
1750₽
+7(863 ..показать +7(499) 11-68-239+7(863) 283-85-87 +7(918) 541-01-07 +7(928) 967-89-98
МЦ Ваш Доктор на проспекте Маршала Жукова Ростов-на-Дону; пр-т Маршала Жукова, д. 31 ;
Запись
1750₽
+7(495 ..показать +7(499) 11-68-239+7(495) 707-10-10 +7(495) 364-29-45
СлимХауз в Золоторожском проезде Москва; Золоторожский пр-д, д. 2 ; м. Площадь Ильича
Запись
1800₽
+7(812 ..показать +7(499) 11-68-239+7(812) 561-45-68
XXI век на Большом Сампсониевском проспекте Санкт-Петербург; Большой Сампсониевский пр-т, д. 45 ; м. Выборгская
Запись
1990₽
+7(499 ..показать +7(499) 11-68-239
MedSwiss на проспекте Обуховской Обороны Санкт-Петербург; пр-т Обуховской Обороны, д. 120Б ; м. Пролетарская
Запись
2000₽
+7(499 ..показать +7(499) 11-68-239
Чудо Доктор на Школьной 46 Москва; ул. Школьная, д. 46 ; м. Римская
Запись
2220₽
+7(861 ..показать +7(499) 11-68-239+7(861) 205-50-50
Евромед на Памяти Чернобыльцев Краснодар; ул. Памяти Чернобыльцев, д. 1 ;
Запись
2220₽
+7(495 ..показать +7(499) 11-68-239+7(495) 582-72-11 +7(495) 582-76-69 +7(915) 399-20-43 +7(926) 065-49-19
Здоровье в Мытищах Мытищи; ул. Летная, д. 40, корп. 1 ; м. Медведково
Запись
2220₽
+7(861 ..показать +7(499) 11-68-239+7(861) 205-50-50
Евромед на Федора Лузана Краснодар; ул. Федора Лузана, д. 19 ;
Запись
2300₽
+7(812 ..показать +7(499) 11-68-239+7(812) 244-31-22
МИБС на Есенина Санкт-Петербург; ул. Есенина, д. 2, корп. 3 ; м. Озерки
Запись
2900₽
+7(495 ..показать +7(499) 11-68-239+7(495) 684-12-98 +7(495) 688-63-36 +7(495) 684-26-45
Поликлиника Центросоюза на Гиляровского Москва; ул. Гиляровского д. 57 ; м. Проспект Мира
Запись
2990₽
+7(499 ..показать +7(499) 11-68-239+7(499) 490-89-29
Бест Клиник на Новочерёмушкинской Москва; ул. Новочерёмушкинская, д. 34, корп. 2 ; м. Профсоюзная
Запись
3200₽
+7(495 ..показать +7(499) 11-68-239+7(495) 682-78-12 +7(495) 682-79-12
Лагуна Мед на Кондратюка Москва; ул. Кондратюка, д. 2 ; м. ВДНХ
Запись
3200₽
+7(495 ..показать +7(499) 11-68-239+7(495) 949-96-80 +7(499) 493-24-00 +7(909) 974-33-88
МЦ Медик на Нелидовской Москва; ул. Нелидовская, д. 20, корп. 1 ; м. Сходненская
Запись
3450₽
+7(343 ..показать +7(499) 11-68-239+7(343) 254-66-66 +7(343) 235-15-55 +7(343) 204-73-75
МЦ Гармония на Родонитовой Екатеринбург; ул. Родонитовая, д. 1 ; м. Ботаническая
Запись
3500₽
+7(495 ..показать +7(499) 11-68-239+7(495) 645-33-77
Ильинская больница в Глухово Московская область; д. Глухово, ул. Рублевское предместье, д. 2, корп. 2 ;
Ещё клиник - 841 . Используйте фильтры